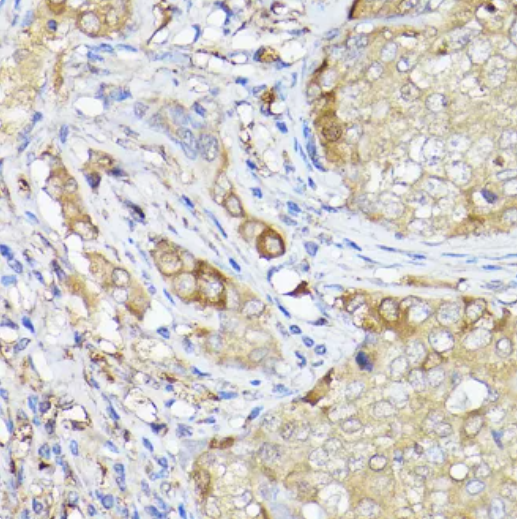
1750386250670880.png QQ_1750386251196.png

更新时间:2025-11-06
点击次数:228
细胞器标志物是指某些细胞器上特异性表达的蛋白质或其他标记物,细胞器标志物抗体是细胞生物学中常用的研究工具。靶向特定的抗体有助于了解蛋白的亚细胞定位以及探究其生物功能,也可以在细胞器分离提取物的蛋白质印迹分析中用作阳性对照。
自噬体是由细胞自身的膜(如内质网或高尔基体)包裹一部分细胞质形成的囊泡结构。自噬体可以与溶酶体结合,降解其所包裹的内容物,释放出所需的代谢物,以满足细胞自身的代谢需求和某些细胞器的更新。自噬体可以通过自噬过程来降解细胞内的受损细胞器或储存能量的物质,不仅能维持细胞和生物机体的稳态平衡,还可以抵抗病原体感染从而达到保护细胞的作用。
微管相关蛋白1轻链3(MAP1LC3/LC3)是一个广泛使用的自噬标志物,它包含了3个亚型,其中MAP1LC3B是LC3的主要编码基因,MAP1LC3B参与了自噬泡的形成,对于维持细胞稳态至关重要。MAP1LC3B定位于细胞质、脂质囊泡和自噬体膜等,参与自噬底物的招募、自噬体的运动以及自噬基因的转录等。
图1 MAP1LC3B抗体免疫组化结果示意图
(商品货号:K002188P)
自噬接头受体蛋白1(SQSTM1)是一种重要的选择性自噬转运蛋白,包括泛素结合域(UBA)、Keap1相互作用区域和LC3相互作用区域等多种功能区域,SQSTM1可选择性参与清除细胞内受损的细胞器和蛋白质。SQSTM1参与蛋白质降解;调节内质网运输、凋亡和炎症;能够识别并结合泛素化蛋白,并调节包括核转录相关因子2-抗氧化反应元件(NRF2)、核因子κB(NF-κB)和胱天蛋白酶8(CASP8)介导的凋亡等信号通路。

图2 SQSTM1抗体免疫组化结果示意图
(商品货号:K005444P)
自噬相关基因12(ATG12)是一种泛素样蛋白,通过泛素样机制与底物ATG5共价结合,还可形成ATG12-ATG5-ATG16大复合物,对自噬体的形成和扩展至关重要。此外,ATG12与ATG3共同调控线粒体稳态和细胞死亡。ATG12涉及自噬体的形成、膜结合、囊泡束缚以及自噬过程中酶活性等多个方面。

图3 ATG12抗体免疫组化结果示意图
(商品货号:K009933P)
已有一些蛋白被鉴定可用作自噬体标志物(见表1)。
表 1 自噬体标志物
相关产品
产品货号 | 产品名称 |
K002188P | Anti-β-Tubulin Polyclonal Antibody |
K004077P | Anti-MAP1LC3B Polyclonal Antibody |
K005444P | Anti-SQSTM1 Polyclonal Antibody |
K106574P | Anti-SQSTM1 Polyclonal Antibody |
K002241P | Anti-MAP1LC3A Polyclonal Antibody |
K200040M | Anti-MAP1LC3A Monoclonal Antibody |
K009933P | Anti-ATG12 Polyclonal Antibody |
K200090M | Anti-ATG5 Monoclonal Antibody |
K000331P | Anti-ATG7 Polyclonal Antibody |
K101553P | Anti-BECN1 Polyclonal Antibody |
K106533P | Anti-LAMP1 Polyclonal Antibody |